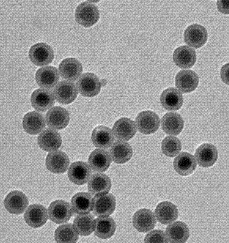
1703229307409678.png 微信截图_20230920144138.png

NaYF4: Yb, Tm@NaYF4上转换纳米粒子
发布时间:2023-12-22 作者:ssl 分享到:
NaYF4: Yb, Tm@NaYF4上转换纳米粒子
NaYF4:Yb,Tm@NaYF4 是一种核壳型上转换纳米粒子,具有钠氟化铒(NaYF4)的核心和壳层的结构,其中核心部分掺杂了铒(Er)和钽(Tm)两种稀土元素。这种设计结构通常用于改善上转换发光性能、提高稳定性以及在生物医学成像和其他领域的应用。
上转换发光: NaYF4:Yb,Tm@NaYF4 纳米粒子具有上转换发光的特性,可以在近红外光激发下发射可见光,有助于提高生物医学成像的深度和分辨率。
多光子激发: 由于 Yb 和 Tm 的共同掺杂,这种纳米粒子可以通过多光子激发实现上转换发光,适用于多光子成像等应用。
核壳结构: 核壳结构提供了对纳米粒子的额外保护,防止核心部分的元素损失,同时提高纳米粒子的生物相容性。
生物医学成像: NaYF4:Yb,Tm@NaYF4 纳米粒子在生物医学成像中有潜在的应用,可以用于细胞标记、活体动态成像等。
磁共振成像: 如果在核心或壳层中引入磁性材料,可以将这些纳米粒子应用于磁共振成像。
药物传递: 这些纳米粒子的表面可以进行修饰,用于药物传递应用,并通过上转换发光实现药物的监测和释放。
光学传感: 上转换发光特性可以用于光学传感应用,如温度传感、离子传感等。
厂家:西安齐岳生物科技有限公司
用途:科研
状态:固体/粉末/溶液
产地:西安
保存:冷藏
温馨提醒:仅供科研,不能用于人体实验
相关产品
葡聚糖包覆稀土掺杂的上转换颗粒
海藻酸钠修饰上转换纳米颗粒
聚乙烯亚胺包覆上转换发光颗粒
环糊精功能化上转换纳米颗粒
PLGA聚合物包裹上转换纳米颗粒
多功能稀土上转换发光纳米材料
PEG修饰水溶性上转换纳米颗粒
PEG包裹上转换荧光纳米颗粒
稀土上转换纳米材料




 齐岳微信公众号
齐岳微信公众号 官方微信
官方微信 库存查询
库存查询